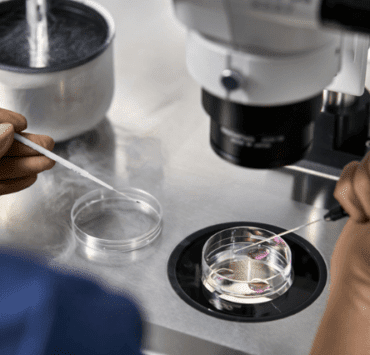
Cum abordăm infertilitatea în cuplu? Sfaturi și reguli de care să ții cont 7 cum-abordăm-infertilitatea-în-cuplu-sfaturi-și-reguli-de-care-să-ții-cont

Top 10 cauze frecvente ale vertijului

Vertijul este un simptom complex, nespecific și care poate determina un înalt grad de îngrijorare în rândul pacienților. De asemenea, vertijul este un simptom frecvent întâlnit, unele statistici menționându-l ca fiind a doua cea mai frecventă cauză de prezentare la medic în rândul adulților.
Vertijul afectează simțul orientării spațiale și se manifestă printr-o senzație de amețeală, un sentiment de pierdere a echilibrului. De asemenea, vertijul poate provoca o senzație de rău în mișcare sau în repaus. Vertijul afectează organele senzoriale, în special ochii și urechile, astfel încât uneori poate provoca leșin.
Vertijul nu este un diagnostic. Este un simptom a cărui cauză poate fi foarte diferită.
În general, se folosesc termeni precum „amețeli” și „vertij” în mod superpozabil. Dar, în timp ce atât amețelile, cât și vertijul sunt considerate probleme de echilibru, cele două simptome sunt diferite. Amețeala este un sentiment general de dezechilibru. În vertij ai senzația că te învârți sau că mediul se rotește în jurul tău.
Vertijul poate dura secunde sau minute sau poate fi persistent și adesea incapacitant, mai ales când este asociat cu greață și vărsăturile. Poate fi problematic, mai ales pentru cei care efectuează o sarcină dificilă sau periculoasă, cum ar fi condusul unui autoturism, zborul sau operarea unor mașini grele.
Tipuri de vertij
Sunt descrise două forme de vertij: central și periferic.
- Vertijul periferic este cel mai frecvent tip de vertij (80% dintre cazuri) și este produs de afecțiuni ale urechii interne, care controlează echilibrul.
- Vertijul central este provocat de o boală sau o leziune de la nivel cerebral (20% dintre cazuri).
Descoperă 10 dintre cele mai frecvente cauze ale vertijului.
1. Hipotensiunea posturală
Cunoscută și ca hipotensiune ortostatică, ea reprezintă o scădere bruscă a tensiunii arteriale în momentul în care pacientul se ridică din culcat în șezut sau din șezut în picioare, repede. Apare la persoanele hipotensive, mai frecvent.
Pentru a verifica dacă suferi de hipotensiune ortostatică, măsoară-ți tensiunea arterială în poziție culcată și compar-o cu cea înregistrată când stai așezată sau în picioare. Dacă diferența este mai mare de 20 mm HG, e posibil că această să fie cauza pentru vertij.
2. Problemele de circulație
Starea generală de sănătate a aparatului cardiovascular poate declanșa simptome de amețeală. Anemia, fluctuațiile hormonale, ateroscleroza, deshidratarea sunt printre cele mai frecvente cauze. Unele studii susțin că bolile cardiovasculare sunt printre cele mai frecvente cauze ale vertijului.
3. Afecțiunile neurologice
Există unele modificări funcționale și structurale ale creierului care pot evolua însoțite de acest simptom. Printre ele se numără:
- Neurodegenerescența: scleroză multiplă sau boală Parkinson determină pierderea capacității nervilor de a comunica;
- Accidentele vasculare cerebrale;
- Tumorile cerebrale.
4. Stresul, anxietatea și depresia
Depresia și anxietatea sunt privite adesea ca fiind probleme pur psihologice, dar ele au efecte fizice concrete asupra modului de funcționare a organismului. Expunerea excesivă la stres, atacurile de panică, anxietatea prelungită și negestionată pot determina dereglarea funcționării sistemului nervos. Din păcate, aceste cauze sunt adesea trecute cu vederea de către specialișți.
5. Vertijul cervicogenic
Afecțiunile coloanei cervicale pot determina apariția de mesaje neuronale eronate și apariția vertijului. Acest tip de amețeli apare mai frecvent consecutiv contuziilor, artritei inflamatorii și la persoanele care suferă de dureri cronice în zona gâtului. Fizioterapia (prin relaxarea musculaturii profunde și scăderea inflamației) și kinetoterapia (prin tonifierea musculaturii, creșterea mobilității și corectarea posturii) tratează eficient acest gen de problemă.
6. Migrenele
Migrenele sunt determinate adeseori de un flux modificat al sângelui și al impulsurilor nervoase la nivelul creierului. Majoritatea pacienților care suferă de migrene menționează vertijul ca simptom asociat crizelor.
Atunci când migrenele se asociază constant cu vertij, medicul poate diagnostica migrena vestibulară, care se poate ameliora cu tratament medicamentos.
7. Unele medicamente
Unele medicamente pot avea efecte secundare manifestate la nivelul urechii interne, al echilibrului hormonal sau al circulației. Printre medicamentele cel mai frecvent incriminate pentru apariția vertijului de numără:
- aspirina și diureticele: vertijul pe care îl determină dispare la întreruperea tratamentului;
- antibioticele aminoglicozidice: pot avea efect ototoxic permanent, determinând amețeli și pierderi de echilibru;
- medicața anticancer: poate avea efect permanent.
8. Hipoglicemia
O scădere bruscă a glicemiei poate determina vertij. Ea se poate întâlni în destul de multe situații, relativ variate:
- diabetici care nu respectă tratamentul și programul de mese;
- consum excesiv de alcool;
- efort fizic excesiv, cu hidratare insuficientă.
9. Problemele de respirație
Persoanele cu afecțiuni respiratorii severe pot trece prin episoade de vertij că urmare a lipsei de oxigen. Vertijul poate apărea, însă, și la persoane perfect sănătoase care trec printr-un episod de hiperventilație, ca urmare a unui atac de panică, de pildă.
10. Disfuncțiile vestibulare
Este una dintre cele mai frecvente cauze ale vertijului, problema regăsindu-se la nivelul urechii interne sau al modului în care se conectează ea la sistemul nervos central. Disfuncțiile vestibulare pot apărea în:
- infecțiile urechii interne-pot afecta nervul vestibulocohlear care la rândul lui influențează echilibrul și auzul;
- afecțiuni vestibulare centrale;
- contuzii și traumatisme craniene.
- Sindromul Meniere se manifestă pe fondul existenței unui exces de lichid în urechea internă. Apare mai des la persoanele cu vârstă cuprinsă între 40 și 60 de ani,crizele pot dura între 20 de minute și 24 de ore și sunt însoțite de pierderea temporară a auzului,auz înfundat, greață, vărsături, tinitus (țiuitul urechii).
Uneori, cauzele vertijului sunt dificil de identificat, chiar de către specialiști. O abordare integrată și colaborarea medicilor de diferite specializări se pot dovedi de mare ajutor în acest caz, întrucât uneori coexistă mai multe dintre cauzele menționate mai sus.